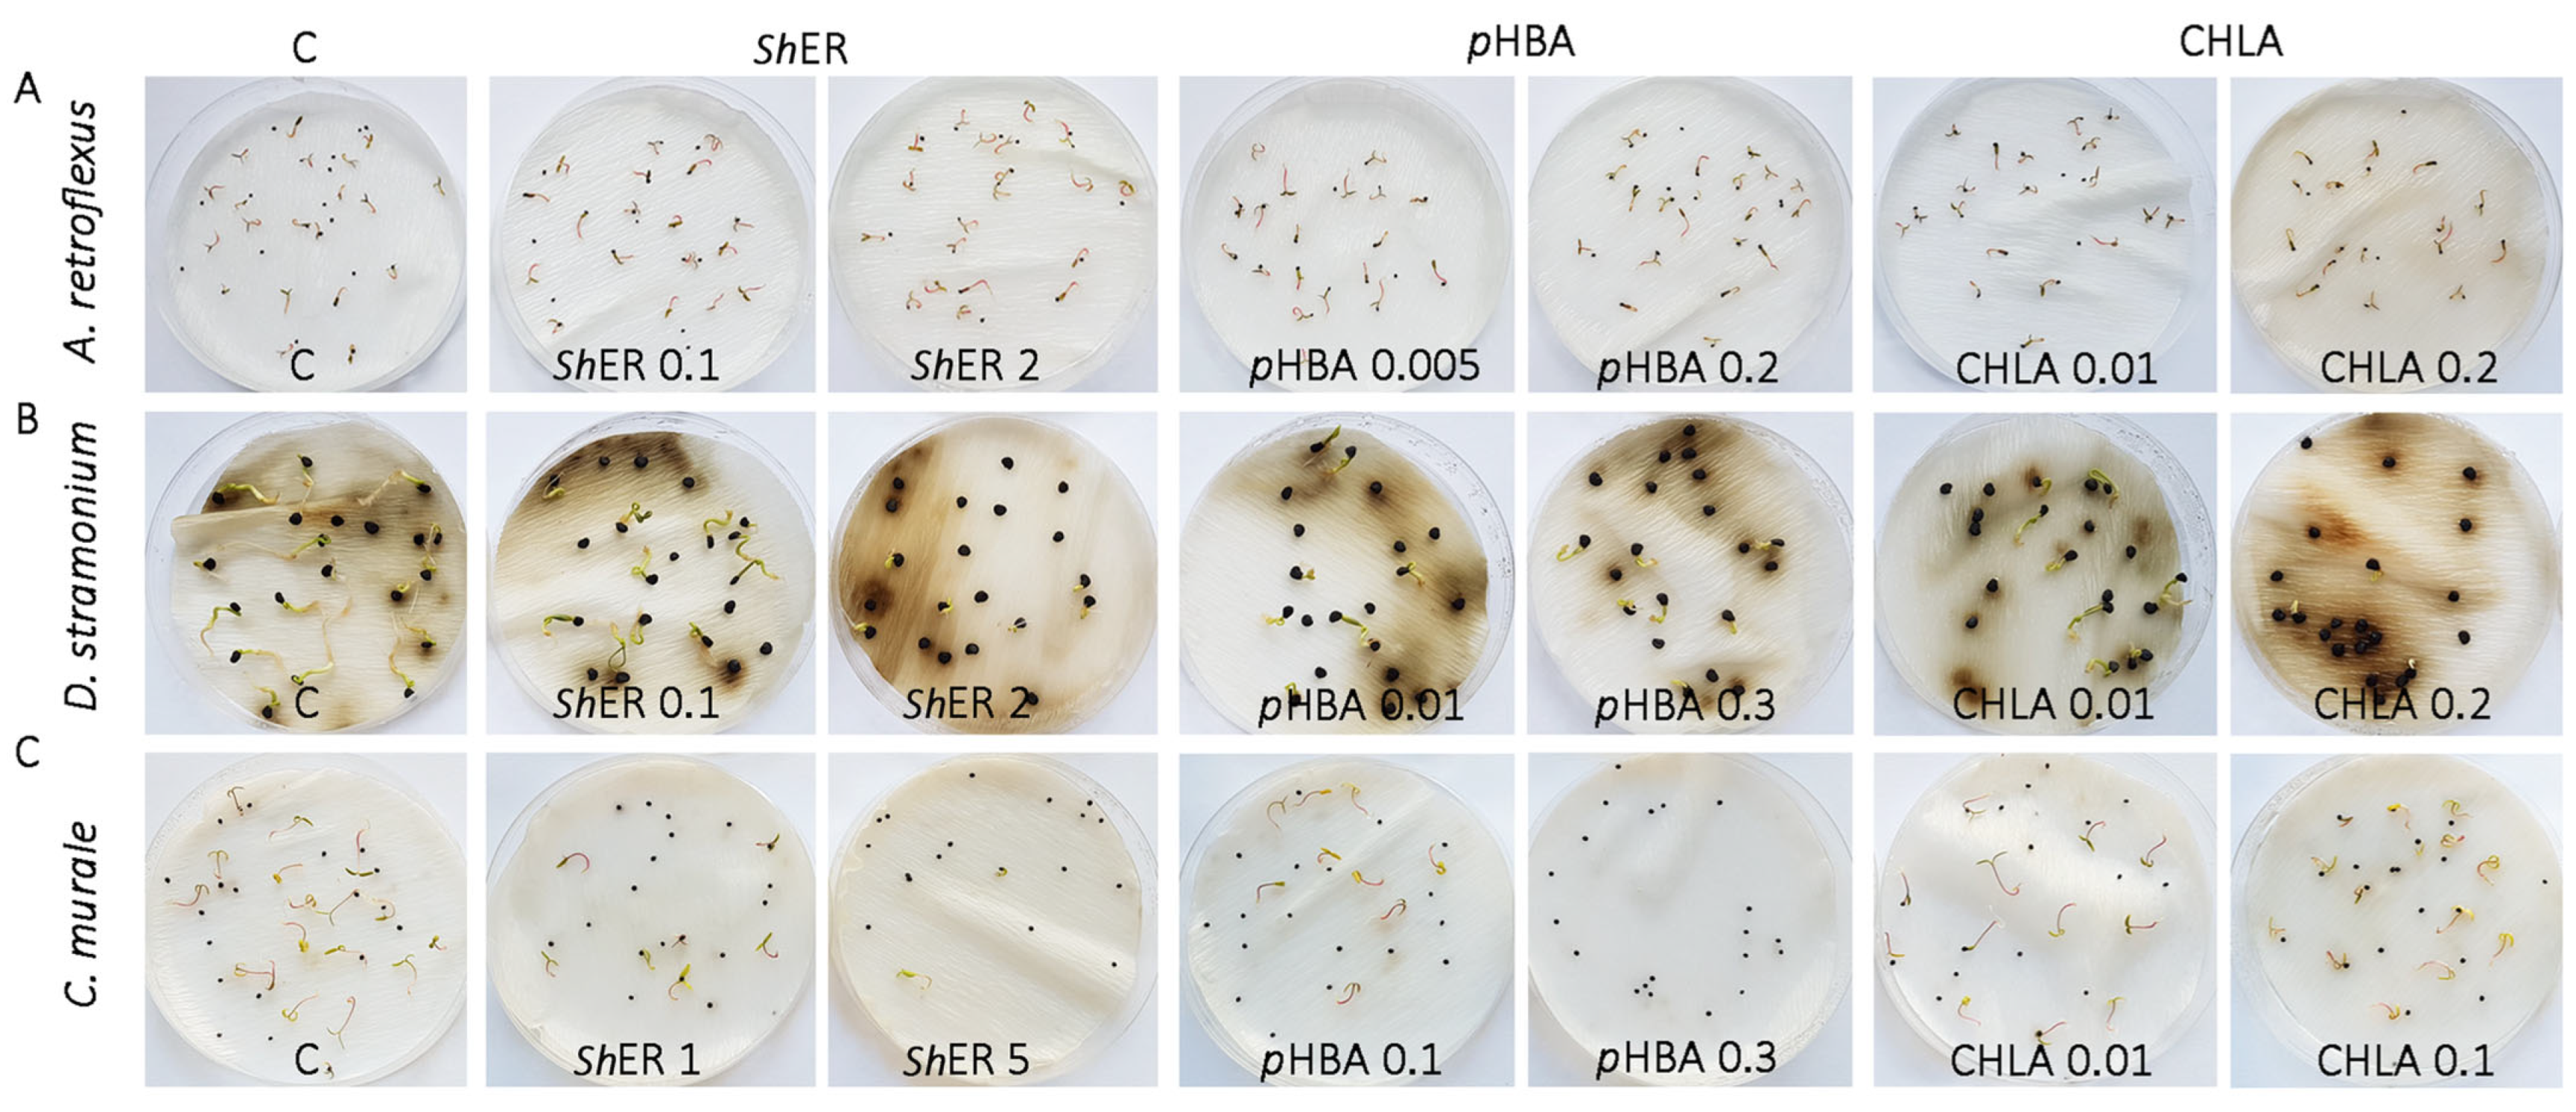
Molecules 30 03060 g002

Bioherbicidal Evaluation of Methanol Extract of Sorghum halepense L. Rhizome and Its Bioactive Components Against Selected Weed Species
Abstract
1. Introduction
2. Results and Discussion
2.1. Untargeted Metabolomics of Sorghum halepense Reveals Organ-Specific Metabolite Profiles
2.2. pHBA and CHLA Are the Major Phenolics of S. halepense Rhizomes
2.3. pHBA and CHLA Are Drivers of S. halepense Phytotoxicity at the Germination Stage of A. retroflexus, D. rtramonium, and Ch. murale Seeds
2.4. Methanol Extract of S. halepense Rhizome and Its Major Constituents, pHBA and CHLA, Affect Early Seedling Growth of A. retroflexus, D. stramonium, and Ch. murale
2.5. Methanol Extract of S. halepense Rhizome, pHBA, and CHLA Modulate the Activities of Antioxidant Enzymes in Ch. murale Seedlings
3. Materials and Methods
3.1. Plant Material
3.2. LC-ESI-QTOF-MS/MS Non-Targeted Metabolomics of S. halepense Methanol Extract
3.3. Preparation of Dry Extract of S. halepense Rhizomes and Its UHPLC/DAD/(–)HESI–MS2 Metabolic Profiling
3.4. Preparation of Working Solutions of S. halepense Extract, pHBA, and CHLA
3.5. Sorghum halepense Phytotoxicity Bioassay Against Selected Weeds
3.5.1. Seed Germination and Seedling Growth of A. retroflexus, D. stramonium, and Ch. murale
3.5.2. Determination of Catalase, Peroxidase, and Superoxide Dismutase Activities in Chenopodiastrum murale L. Seedlings
3.6. Statistical Analyses
4. Conclusions
Supplementary Materials
Author Contributions
Funding
Institutional Review Board Statement
Informed Consent Statement
Data Availability Statement
Conflicts of Interest
Abbreviations
| CAT | catalase |
| CHLA | chlorogenic acid |
| DT | days after the start of the treatment |
| HCA | hierarchical cluster analysis |
| Native PAGE | native polyacrylamide gel electrophoresis |
| PCA | principal component analysis |
| pHBA | p-hydroxybenzoic acid |
| POX | peroxidase |
| ROS | reactive oxygen species |
| ShER | methanol extract of S. halepense rhizomes |
| SOD | superoxide dismutase |
References
- Global Invasive Species Database Species Profile: Sorghum halepense. 2025. Available online: http://www.iucngisd.org/gisd/speciesname/Sorghum+halepense (accessed on 22 June 2025).
- Chirita, R.; Grozea, I.; Sarpe, N.; Lauer, K.F. Control of Sorghum halepense (L.) Species in Western Part of Romania. Commun. Agric. Appl. Biol. Sci. 2007, 73, 959–964. Available online: https://pubmed.ncbi.nlm.nih.gov/19226849 (accessed on 23 June 2025).
- Yazlik, A.; Üremiş, İ. Impact of Sorghum halepense (L.) Pers. on the Species Richness in Native Range. Phytoparasitica 2022, 50, 1107–1122. [Google Scholar] [CrossRef]
- Petrova, A.; Vladimirov, V.; Georgiev, V. Invasive Alien Species of Vascular Plants in Bulgaria; Institute of Biodiversity and Ecosystem Research, Bulgarian Academy of Sciences: Sofia, Bulgaria, 2013. [Google Scholar]
- Lazarević, P.; Stojanović, V.; Jelić, I.; Perić, R.; Krsteski, B.; Ajtić, R.; Sekulić, N.; Branković, S.; Sekulić, G.; Bjedov, V. Preliminarni Spisak Invazivnih Vrsta u Republici Srbiji sa Opštim Merama Kontrole i Suzbijanja kao Potpora Budućim Zakonskim Aktima. Zaštita Prir. 2012, 62, 5–28. [Google Scholar]
- Stojanović, V.; Bjedov, I.; Jovanović, I.; Jelić, I.; Obratov-Petković, D.; Nešić, M.; Nedeljković, D. Odabrane Invazivne Strane Vrste u Flori Srbije—Građa za Izradu Nacionalnog Propisa o Sprečavanju Unošenja i Širenja Invazivnih Stranih Vrsta i Njihovom Upravljanju; Zavod za Zaštitu Prirode Srbije: Beograd, Serbia, 2021. [Google Scholar]
- Yang, M.; Zhao, H.; Xian, X.; Qi, Y.; Li, Q.; Guo, J.; Chen, L.; Liu, W. Reconstructed Global Invasion and Spatio-Temporal Distribution Pattern Dynamics of Sorghum halepense under Climate and Land-use change. Plants 2023, 12, 3128. [Google Scholar] [CrossRef] [PubMed]
- Peerzada, A.M.; Ali, H.H.; Hanif, Z.; Bajwa, A.A.; Kebaso, L.; Frimpong, D.; Chauhan, B.S. Eco-Biology, Impact, and Management of Sorghum halepense (L.) Pers. Biol. Invas. 2017, 19, 955–973. [Google Scholar] [CrossRef]
- Secretariat of the International Plant Protection Convention (IPPC). Diagnostic Protocols for Regulated Pests DP 19: Sorghum halepense; Food and Agricultural Organization of the United Nations, International Plant Protection Convention: Rome, Italy, 2017; 22p. [Google Scholar]
- Nouri, H.; Talab, Z.A.; Tavassoli, A. Effect of Weed Allelopathic of Sorghum (Sorghum halepense) on Germination and Seedling Growth of Wheat, Alvand Cultivar. Ann. Biol. Res. 2012, 3, 1283–1293. [Google Scholar]
- Rout, M.E.; Chrzanowski, T.H.; Smith, W.K.; Gough, L. Ecological Impacts of the Invasive Grass Sorghum halepense on Native Tallgrass Prairie. Biol. Invas. 2013, 15, 327–339. Available online: https://link.springer.com/article/10.1007/s10530-012-0289-7 (accessed on 23 June 2025). [CrossRef]
- Weston, L.A.; Alsaadawi, I.S.; Baerson, S.R. Sorghum Allelopathy—From Ecosystem to Molecule. J. Chem. Ecol. 2013, 39, 142–153. Available online: https://link.springer.com/article/10.1007/s10886-013-0245-8 (accessed on 23 June 2025). [CrossRef] [PubMed]
- Majumdar, S.; Sanwal, U.; Inderjit. Interference Potential of Sorghum halepense on Soil and Plant Seedling Growth. Plant Soil 2017, 418, 219–230. [Google Scholar] [CrossRef]
- Hussain, M.I.; Danish, S.; Sánchez-Moreiras, A.M.; Vicente, Ó.; Jabran, K.; Chaudhry, U.K.; Reigosa, M.J. Unraveling Sorghum Allelopathy in Agriculture: Concepts and Implications. Plants 2021, 10, 1795. [Google Scholar] [CrossRef] [PubMed]
- Abdul-Wahab, A.S.; Rice, E.L. Plant Inhibition by Johnson grass and its Possible Significance in Old-Field Succession. Bull. Torrey Bot. Club 1967, 94, 486–497. [Google Scholar] [CrossRef]
- Nicollier, G.F.; Pope, D.F.; Thompson, A.C. Biological Activity of Dhurrin and Other Compounds from Johnson Grass (Sorghum halepense). J. Agric. Food Chem. 1983, 31, 744–748. [Google Scholar] [CrossRef]
- Liu, Y.; Zhang, C.X.; Wei, S.H.; Meng, Q.H. Allelopathic Potential of Subterranean Parts of Sorghum halepense (L.) Pers. Acta Phytophylacica Sin. 2010, 37, 273–276. [Google Scholar]
- Knezevic, S.Z.; Horak, M.J. Influence of Emergence Time and Density on Redroot Pigweed (Amaranthus retroflexus). Weed Sci. 1998, 46, 665–672. [Google Scholar] [CrossRef]
- Saayman-du Toit, A.E.J. Effect of Plant Density, Weed-Crop Interference and Water Stress on Seed Germination of Datura stramonium L. S. Afr. J. Plant Soil 2000, 17, 113–116. [Google Scholar] [CrossRef]
- Raza, A.; Ali, H.H.; Zaheer, M.S.; Iqbal, J.; Seleiman, M.F.; Sattar, J.; Chauhan, B.S. Bio-Ecology and the Management of Chenopodiastrum murale L.: A Problematic Weed in Asia. Crop Prot. 2023, 172, 106332. [Google Scholar] [CrossRef]
- Khattak, W.A.; Sun, J.; Hameed, R.; Zaman, F.; Abbas, A.; Khan, K.A.; Elboughdiri, N.; Akbar, R.; He, F.; Ullah, M.W.; et al. Unveiling the Resistance of Native Weed Communities: Insights for Managing Invasive Weed Species in Disturbed Environments. Biol. Rev. 2024, 99, 753–777. [Google Scholar] [CrossRef] [PubMed]
- Kostina-Bednarz, M.; Płonka, J.; Barchanska, H. Allelopathy as a Source of Bioherbicides: Challenges and Prospects for Sustainable Agriculture. Rev. Environ. Sci. Biotechnol. 2023, 22, 471–504. [Google Scholar] [CrossRef]
- Nath, C.P.; Singh, R.G.; Choudhary, V.K.; Datta, D.; Nandan, R.; Singh, S.S. Challenges and Alternatives of Herbicide-Based Weed Management. Agronomy 2024, 14, 126. [Google Scholar] [CrossRef]
- Hickman, D.T. Cropping System Redesign for Allelopathy: A Vsion for the ‘Post-Herbicide Era’. Weed Res. 2025, 65, e70022. [Google Scholar] [CrossRef]
- Li, J.; Tian, C.; Wang, M.; Liu, L.; Li, M.; Ma, S.; Dong, J. Inhibition Effects of Extracts from 113 Plant Species on the Germination and Growth of Amaranthus retroflexus and Digitaria sanguinalis. Chin. J. Biol. Control 2022, 38, 374. Available online: http://www.zgswfz.com.cn/EN/10.16409/j.cnki.2095-039x.2021.05.018 (accessed on 23 June 2025).
- Miloudi, S.; Abbad, I.; Soulaimani, B.; Ferradous, A.; Abbad, A.; El Mouden, E.H. Optimization of Herbicidal Activity of Essential Oil Mixtures from Satureja alpina, Thymus satureioides and Myrtus communis on Seed Germination and Post-Emergence Growth of Amaranthus retroflexus L. Crop Prot. 2024, 180, 106642. [Google Scholar] [CrossRef]
- Wei, D.; Junliang, L.; Zhuo, C.; Peng, C. Dormancy of Amaranthus retroflexus L. Seeds and Physiological Response Seedlings to Acifluorfen Sodium. J. Northeast Agric. Univ. 2024, 31, 1–10. [Google Scholar]
- Qasem, J.R. Allelopathic Effects of Amaranthus retroflexus and Chenopodiastrum murale on Vegetable Crops. Allelopath. J. 1995, 2, 49–66. [Google Scholar]
- Rezaie, F.; Yarnia, M. Allelopathic Effects of Chenopodiastrum album, Amaranthus retroflexus, and Cynodon dactylon on Germination and Growth of Safflower. J. Food Agric. Environ. 2009, 7, 516–521. [Google Scholar]
- Lovett, J.V.; Levitt, J.U.D.Y.; Duffield, A.M.; Smith, N.G. Allelopathic Potential of Datura stramonium L. (Thorn-Apple). Weed Res. 1981, 21, 165–170. [Google Scholar] [CrossRef]
- Cai, S.L.; Mu, X.Q. Allelopathic Potential of Aqueous Leaf Extracts of Datura stramonium L. on Seed Germination, Seedling Growth, and Root Anatomy of Glycine max (L.) Merrill. Allelopath. J. 2012, 30, 235–246. [Google Scholar]
- Elisante, F.; Tarimo, M.T.; Ndakidemi, P.A. Allelopathic Effect of Seed and Leaf Aqueous Extracts of Datura stramonium on Leaf Chlorophyll Content, Shoot and Root Elongation of Cenchrus ciliaris and Neonotonia wightii. Am. J. Plant Sci. 2013, 4, 2332–2339. [Google Scholar] [CrossRef]
- Dmitrović, S.; Simonović, A.; Mitić, N.; Savić, J.; Cingel, A.; Filipović, B.; Ninković, S. Hairy Root Exudates of Allelopathic Weed Chenopodium murale L. Induce Oxidative Stress and Down-Regulate Core Cell Cycle Genes in Arabidopsis and Wheat Seedlings. Plant Growth Regul. 2015, 75, 365–382. [Google Scholar] [CrossRef]
- Mor, A.; Kumar, M.; Nara, R.; Singh, R. A Study on the Allelopathic Impact of Chenopodiastrum murale L. on Wheat Crop Plants. Bio. Sci. Res. Bull. 2022, 38, 95–99. Available online: https://www.journals.acspublisher.com/index.php/bsrb/article/view/8332 (accessed on 23 June 2025). [CrossRef]
- Al-Andal, A.; Radwan, A.M.; Donia, A.M.; Balah, M.A. Allelopathic Pathways and Impacts of Chenopodiastrum Species via Leachates, Decaying Residues, and Essential Oils. PLoS ONE 2025, 20, e0321782. [Google Scholar] [CrossRef] [PubMed]
- Khan, A.M.; Mobli, A.; Werth, J.A.; Chauhan, B.S. Germination and Seed Persistence of Amaranthus retroflexus and Amaranthus viridis: Two Emerging Weeds in Australian Cotton and Other Summer Crops. PLoS ONE 2022, 17, e0263798. [Google Scholar] [CrossRef] [PubMed]
- Ghanizadeh, H.; Lorzadeh, S.; Aryannia, N. Effect of Weed Interference on Zea mays: Growth Analysis. Weed Biol. Manag. 2014, 14, 133–137. [Google Scholar] [CrossRef]
- Wang, H.; Guo, W.; Zhang, L.; Zhao, K.; Ge, L.; Lv, X.; Wang, J. Multiple Resistance to Thifensulfuron-Methyl and Fomesafen in Redroot Pigweed (Amaranthus retroflexus L.) from China. Chil. J. Agric. Res. 2017, 77, 311–317. [Google Scholar] [CrossRef]
- Karimmojeni, H.; Rahimian, H.; Alizadeh, H.; Yousefi, A.R.; Gonzalez-Andujar, J.L.; Sweeney, E.M.; Mastinu, A. Competitive Ability Effects of Datura stramonium L. and Xanthium strumarium L. on the Development of Maize (Zea mays) Seeds. Plants 2021, 10, 1922. [Google Scholar] [CrossRef] [PubMed]
- Bajwa, A.A.; Zulfiqar, U.; Sadia, S.; Bhowmik, P.; Chauhan, B.S. A Global Perspective on the Biology, Impact and Management of Chenopodiastrum album and Chenopodiastrum murale: Two Troublesome Agricultural and Environmental Weeds. Environ. Sci. Pollut. Res. 2019, 26, 5357–5371. [Google Scholar] [CrossRef] [PubMed]
- Adetunji, A.I.; Duodu, K.G.; Taylor, J.R. Inactivation of Tannins in Milled Sorghum Grain through Steeping in Dilute NaOH Solution. Food Chem. 2015, 175, 225–232. [Google Scholar] [CrossRef] [PubMed]
- Woodhead, S.; Cooper-Driver, G. Phenolic Acids and Resistance to Insect Attack in Sorghum bicolor. Biochem. Syst. Ecol. 1979, 7, 309–310. [Google Scholar] [CrossRef]
- Mareya, C.R.; Tugizimana, F.; Piater, L.A.; Madala, N.E.; Steenkamp, P.A.; Dubery, I.A. Untargeted Metabolomics Reveal Defensome-Related Metabolic Reprogramming in Sorghum bicolor Against Infection by Burkholderia andropogonis. Metabolites 2019, 9, 8. [Google Scholar] [CrossRef] [PubMed]
- Kang, J.; Price, W.E.; Ashton, J.; Tapsell, L.C.; Johnson, S. Identification and Characterization of Phenolic Compounds in Hydromethanolic Extracts of Sorghum Wholegrains by LC-ESI-MSn. Food Chem. 2016, 211, 215–226. [Google Scholar] [CrossRef] [PubMed]
- Shrestha, S.; Park, J.H.; Cho, J.G.; Lee, D.Y.; Jeong, R.H.; Song, M.C.; Cho, S.K.; Lee, D.S.; Baek, N.I. Phytochemical Constituents from the Florets of Tiger Grass Thysanolaena latifolia from Nepal. J. Asian Nat. Prod. Res. 2016, 18, 206–213. [Google Scholar] [CrossRef] [PubMed]
- Kundu, P.; Grover, S.; Perez, A.; Raya Vaca, J.D.; Kariyat, R.; Louis, J. Sorghum Defense Responses to Sequential Attack by Insect Herbivores of Different Feeding Guilds. Planta 2023, 258, 35. [Google Scholar] [CrossRef] [PubMed]
- Mattoo, A.K.; Cavigelli, M.A.; Mišić, D.; Gašić, U.; Maksimović, V.; Kramer, M.; Kaur, B.; Matekalo, D.; Nestorović Živković, J.; Roberts, D.P. Maize Metabolomics in Relation to Cropping System and Growing Year. Front. Sustain. Food Syst. 2023, 7, 1130089. [Google Scholar] [CrossRef]
- Mikkelsen, B.L.; Olsen, C.E.; Lyngkjær, M.F. Accumulation of Secondary Metabolites in Healthy and Diseased Barley, Grown under Future Climate Levels of CO2, Ozone and Temperature. Phytochemistry 2015, 118, 162–173. [Google Scholar] [CrossRef] [PubMed]
- Ziółkiewicz, A.; Kasprzak-Drozd, K.; Wójtowicz, A.; Oniszczuk, T.; Gancarz, M.; Kowalska, I.; Mołdoch, J.; Kondracka, A.; Oniszczuk, A. The Effect of In Vitro Digestion on Polyphenolic Compounds and Antioxidant Properties of Sorghum (Sorghum bicolor (L.) Moench) and Sorghum-Enriched Pasta. Molecules 2023, 28, 1706. [Google Scholar] [CrossRef] [PubMed]
- Bortolami, M.; Di Matteo, P.; Rocco, D.; Feroci, M.; Petrucci, R. Metabolic Profile of Agropyron repens (L.) P. Beauv. Rhizome Herbal Tea by HPLC-PDA-ESI-MS/MS Analysis. Molecules 2022, 27, 4962. [Google Scholar] [CrossRef] [PubMed]
- Pontieri, P.; Pepe, G.; Campiglia, P.; Merciai, F.; Basilicata, M.G.; Smolensky, D.; Calcagnile, M.; Troisi, J.; Romano, R.; del Giudice, F.; et al. Comparison of Content in Phenolic Compounds and Antioxidant Capacity in Grains of White, Red, and Black Sorghum Varieties Grown in the Mediterranean Area. ACS Food Sci. Technol. 2021, 1, 1109–1119. [Google Scholar] [CrossRef]
- Ardoin, R.; Smith, B.; Lea, J.; Boue, S.; Smolensky, D.; Santana, A.L.; Peterson, J. Consumer Perceptions and Antioxidant Profiling of Acidified Cold-Brewed Sorghum Bran Beverages. J. Food Sci. 2023, 88, 2301–2312. [Google Scholar] [CrossRef] [PubMed]
- Rocchetti, G.; Chiodelli, G.; Giuberti, G.; Masoero, F.; Trevisan, M.; Lucini, L. Evaluation of Phenolic Profile and Antioxidant Capacity in Gluten-Free Flours. Food Chem. 2017, 228, 367–373. [Google Scholar] [CrossRef] [PubMed]
- Grzybowski, M.W.; Zwiener, M.; Jin, H.; Wijewardane, N.K.; Atefi, A.; Naldrett, M.J.; Alvarez, S.; Ge, Y.; Schnable, J.C. Variation in Morpho-Physiological and Metabolic Responses to Low Nitrogen Stress across the Sorghum Association Panel. BMC Plant Biol. 2022, 22, 433. [Google Scholar] [CrossRef] [PubMed]
- Martinez, O.D.M.; Theodoro, J.M.V.; Grancieri, M.; Toledo, R.C.L.; de Barros, F.A.R.; Tako, E.; Queiroz, V.A.V.; Martino, H.S.D. Dry Heated Sorghum BRS 305 Hybrid Flour as a Source of Resistant Starch and Tannins Improves Inflammation and Oxidative Stress in Wistar Rats Fed with a High-Fat High-Fructose Diet. Food Funct. 2021, 12, 8738–8746. [Google Scholar] [CrossRef] [PubMed]
- Correia, V.T.V.; D’Angelis, D.F.; Queiroz, V.A.V.; Ramos, A.L.C.C.; Macedo, M.C.C.; Augusti, R.; Melo, J.O.F.; Ferreira, A.A.; Lacerda, I.C.A.; Fante, C.A. Impact of Gamma Irradiation on Physicochemical, Technological, Antioxidant and Microbiology Properties of Whole Sorghum Flours. J. Braz. Chem. Soc. 2023, 34, 182–193. [Google Scholar] [CrossRef]
- Eysseric, E.; Ghislain, T.; Duret, X.; Lalonde, O.; Segura, P.A.; Lavoie, J.M. Effect of Steam Treatments on the Availability of Various Families of Secondary Metabolites Extracted from Green Sweet Sorghum. Ind. Crops Prod. 2017, 104, 120–128. [Google Scholar] [CrossRef]
- Kang, H.R.; Yun, H.S.; Lee, T.K.; Lee, S.; Kim, S.H.; Moon, E.; Park, K.M.; Kim, K.H. Chemical Characterization of Novel Natural Products from the Roots of Asian Rice (Oryza sativa) that Control Adipocyte and Osteoblast Differentiation. J. Agric. Food Chem. 2018, 66, 2677–2684. [Google Scholar] [CrossRef] [PubMed]
- Wu, S.B.; Meyer, R.S.; Whitaker, B.D.; Litt, A.; Kennelly, E.J. A New Liquid Chromatography-Mass Spectrometry-Based Strategy to Integrate Chemistry, Morphology, and Evolution of Eggplant (Solanum) Species. J. Chromatogr. A 2013, 1314, 154–172. [Google Scholar] [CrossRef] [PubMed]
- Cadahía, E.; Fernández de Simón, B.; Aranda, I.; Sanz, M.; Sánchez-Gómez, D.; Pinto, E. Non-Targeted Metabolomic Profile of Fagus sylvatica L. Leaves using Liquid Chromatography with Mass Spectrometry and Gas Chromatography with Mass Spectrometry. Phytochem. Anal. 2015, 26, 171–182. Available online: https://pubmed.ncbi.nlm.nih.gov/25516018 (accessed on 23 June 2025). [CrossRef] [PubMed]
- Abu-Reidah, I.M.; Gil-Izquierdo, Á.; Medina, S.; Ferreres, F. Phenolic Composition Profiling of Different Edible Parts and By-Products of Date Palm (Phoenix dactylifera L.) by using HPLC-DAD-ESI/MSⁿ. Food Res. Int. 2017, 100, 494–500. [Google Scholar] [CrossRef] [PubMed]
- Zheng, Y.F.; Li, D.Y.; Sun, J.; Cheng, J.M.; Chai, C.; Zhang, L.; Peng, G.P. Comprehensive Comparison of Two Color Varieties of Perillae folium using Rapid Resolution Liquid Chromatography Coupled with Quadruple-Time-of-Flight Mass Spectrometry (RRLC-Q/TOF-MS)-Based Metabolic Profile and In Vivo/In Vitro Anti-Oxidative Activity. J. Agric. Food Chem. 2020, 68, 14684–14697. [Google Scholar] [CrossRef] [PubMed]
- Huang, H.; Liu, C.; Wei, S.; Wang, J.; Zhang, C. Dynamic Root Exudation of Phenolic Allelochemicals from Johnson Grass (Sorghum halepense). Weed Biol. Manag. 2015, 15, 133–137. [Google Scholar] [CrossRef]
- Williamson, G.B.; Weidenhamer, J.D. Bacterial Degradation of Juglone. J. Chem. Ecol. 1990, 16, 1739–1742. [Google Scholar] [CrossRef] [PubMed]
- Huang, H.J.; Zhang, C.X.; Meng, Q.H.; Wei, S.H.; Liu, Y.; Cui, H.L. Allelopathic Potential of Invasive Alien Weed Sorghum halepense (L.) Pers. Chin. J. Ecol. 2008, 27, 1234–1237. Available online: https://www.cje.net.cn/EN/Y2008/V27/I07/1234 (accessed on 23 June 2025).
- Uremis, I.; Arslan, M.; Uludag, A.; Sangun, M. Allelopathic Potentials of Residues of 6 Brassica Species on Johnson Grass (Sorghum halepense L. Pers.). Afr. J. Biotechnol. 2010, 8, 3497–3501. Available online: https://www.ajol.info/index.php/ajb/article/view/61834 (accessed on 23 June 2025).
- Javaid, A.; Naqvi, S.F.; Shoaib, A. Antifungal Activity of Methanolic Extracts of Sorghum halepense Against Macrophomina phaseolina. Afr. J. Microbiol. Res. 2012, 6, 5814–5818. Available online: https://academicjournals.org/journal/AJMR/article-full-text-pdf/6F1103039908 (accessed on 23 June 2025). [CrossRef]
- Shah, M.A.R.; Khan, R.A.; Ahmed, M. Sorghum halepense (L.) Pers Rhizomes Inhibitory Potential Against Diabetes and Free Radicals. Clin. Phytosci. 2021, 7, 19. [Google Scholar] [CrossRef]
- Reigosa, M.J.; Souto, X.C.; Gonzalez, L. Effect of Phenolic Compounds on the Germination of Six Weeds Species. Plant Growth Reg. 1999, 28, 83–88. [Google Scholar] [CrossRef]
- Al Sakran, M.; Almhemed, K.; Ustuner, T.; Dal, S. Effect of Aqueous Extract of Sorghum halepense (L.) Pers. on Germination and Growth of Some Weed Species. Int. J. Sci. Res. Publ. 2021, 11, 404–408. Available online: https://www.ijsrp.org/research-paper-0121/ijsrp-p10946.pdf (accessed on 23 June 2025). [CrossRef]
- Yarnia, M.; Benam, M.K.; Tabrizi, E.F.M. Allelopathic Effects of Sorghum Extracts on Amaranthus retroflexus Seed Germination and Growth. J. Food Agric. Environ. 2009, 7, 770–774. [Google Scholar]
- Tigre, R.C.; Silva, N.H.; Santos, M.G.; Honda, N.K.; Falcao, E.P.S.; Pereira, E.C. Allelopathic and Bioherbicidal Potential of Cladonia verticillaris on the Germination and Growth of Lactuca sativa. Ecotoxicol. Environ. Saf. 2012, 84, 125–132. [Google Scholar] [CrossRef] [PubMed]
- Li, Z.H.; Wang, Q.; Ruan, X.; Pan, C.D.; Jiang, D.A. Phenolics and Plant Allelopathy. Molecules 2010, 15, 8933–8952. [Google Scholar] [CrossRef] [PubMed]
- Cheng, F.; Cheng, Z. Research Progress on the Use of Plant Allelopathy in Agriculture and the Physiological and Ecological Mechanisms of Allelopathy. Front. Plant Sci. 2015, 6, 1020. [Google Scholar] [CrossRef] [PubMed]
- Qun-Hui, L.I.N.; Hua-Qin, H.E.; Wen-Xiong, L.I.N. Study on the Action Characteristics of Allelochemicals in Rice. Chin. J. Eco-Agric. 2001, 9, 84–85. Available online: https://ecoagri.ac.cn/en/article/id/2001129 (accessed on 23 June 2025).
- Toaima, S.A.; Lamlom, M.M.; Abdel-Wahab, T.I.; Abdel-Wahab, S.I. Allelopathic Effects of Sorghum and Sudan Grass on Some Following Winter Field Crops. Int. J. Plant Soil Sci. 2014, 3, 599–622. [Google Scholar] [CrossRef] [PubMed]
- Dmitrović, S.; Mitić, N.; Budimir, S.; Janošević, D.; Živković, S.; Skorić, M.; Ninković, S. Morpho-Histological and Bioherbicidal Evaluation of Wild-Type and Transformed Hairy Roots of Goosefoot. S. Afr. J. Bot. 2015, 96, 53–61. [Google Scholar] [CrossRef]
- Dmitrović, S.; Perišić, M.; Stojić, A.; Živković, S.; Boljević, J.; Nestorović Živković, J.; Aničić, N.; Ristić, M.; Mišić, D. Essential Oils of Two Nepeta Species Inhibit Growth and Induce Oxidative Stress in Ragweed (Ambrosia artemisiifolia L.) Shoots In Vitro. Acta Physiol. Plant. 2015, 37, 64. [Google Scholar] [CrossRef]
- Wang, K.; Wang, T.; Ren, C.; Dou, P.; Miao, Z.; Liu, X.; Huang, D.; Wang, K. Aqueous Extracts of Three Herbs Allelopathically Inhibit Lettuce Germination but Promote Seedling Growth at Low Concentrations. Plants 2022, 11, 486. [Google Scholar] [CrossRef] [PubMed]
- Abdul-Wahab, A.S. The Toxicity of Johnson Grass Excretions: A Mechanism of Root Competition. Master’s Thesis, Louisiana State University, Baton Rouge, LA, USA, 1964. [Google Scholar]
- Hallak, A.M.G.; Davide, L.C.; Souza, I.F. Effects of Sorghum (Sorghum bicolor L.) Root Exudates on the Cell Cycle of the Bean Plant (Phaseolus vulgaris L.) Root. Genet. Mol. Biol. 1999, 22, 95–99. [Google Scholar] [CrossRef]
- Asgharipour, M.R.; Armin, M. Inhibitory Effects of Sorghum halepense Root and Leaf Extracts on Germination and Early Seedling Growth of Widely Used Medicinal Plants. Adv. Environ. Biol. 2010, 4, 316–324. [Google Scholar]
- Parks, J.M.; Rice, E.L. Effects of Certain Plants of Old-Field Succession on the Growth of Blue-Green Algae. Bull. Torrey Bot. Club 1969, 96, 345–360. [Google Scholar] [CrossRef]
- Rice, E.L. Allelopathy—An Overview. In Chemically Mediated Interactions Between Plants and Other Organisms; Cooper-Driver, G.A., Swain, T., Conn, E.E., Eds.; Recent Advances in Phytochemistry; Springer: Boston, MA, USA, 1985; Volume 19, pp. 23–45. [Google Scholar]
- Weir, T.L.; Park, S.W.; Vivanco, J.M. Biochemical and Physiological Mechanisms Mediated by Allelochemicals. Curr. Opin. Plant Biol. 2004, 7, 472–479. [Google Scholar] [CrossRef] [PubMed]
- Bogdanović, J.; Radotić, K.; Mitrović, A. Changes in Activities of Antioxidant Enzymes during Chenopodiastrum murale Seed Germination. Biol. Plant. 2008, 52, 396–400. [Google Scholar] [CrossRef]
- Politycka, B. Cell Wall Peroxidases in Cucumber Roots Induced by Phenolic Allelochemicals. Allelopath. J. 2004, 13, 29–36. Available online: https://www.cabidigitallibrary.org/doi/full/10.5555/20043033945 (accessed on 23 June 2025).
- Naz, H.; Akram, N.A.; Ashraf, M.; Hefft, D.I.; Jan, B.L. Leaf Extract of Neem (Azadirachta indica) Alleviates Adverse Effects of Drought in Quinoa (Chenopodiastrum quinoa Willd.) Plants through Alterations in Biochemical Attributes and Antioxidants. Saudi J. Biol. Sci. 2022, 29, 1367–1374. [Google Scholar] [CrossRef] [PubMed]
- Bengyella, L.; Russell, T.R.; Kaminski, J.E. Stimulatory and Inhibitory Role of Allelopathic Chlorogenic Acid in Seed Germination and Seedling Growth of Tall Fescue Grass (Festuca arundinacea Schreb.) via pH Reprogramming. J. Plant Growth Regul. 2023, 42, 6969–6979. [Google Scholar] [CrossRef]
- Arikan, B.; Ozfidan-Konakci, C.; Yildiztugay, E.; Zengin, G.; Alp, F.N.; Elbasan, F. Exogenous Hesperidin and Chlorogenic Acid Alleviate Oxidative Damage Induced by Arsenic Toxicity in Zea mays through Regulating the Water Status, Antioxidant Capacity, Redox Balance and Fatty Acid Composition. Environ. Pollut. 2022, 292, 118389. [Google Scholar] [CrossRef] [PubMed]
- Zhou, X.; Yu, G.; Wu, F. Responses of Soil Microbial Communities in the Rhizosphere of Cucumber (Cucumis sativus L.) to Exogenously Applied p-Hydroxybenzoic Acid. J. Chem. Ecol. 2012, 38, 975–983. [Google Scholar] [CrossRef] [PubMed]
- Jin, X.; Wu, F.; Zhou, X. Different Toxic Effects of Ferulic and p-Hydroxybenzoic Acids on Cucumber Seedling Growth Were Related to Their Different Influences on Rhizosphere Microbial Composition. Biol. Fertil. Soils 2020, 56, 125–136. [Google Scholar] [CrossRef]
- Huang, C.-Z.; Xu, L.; Sun, J.; Zhang, Z.-H.; Fu, M.-L.; Teng, H.-Y.; Yi, K.-K. Allelochemical p-Hydroxybenzoic Acid Inhibits Root Growth via Regulating ROS Accumulation in Cucumber (Cucumis sativus L.). J. Integr. Agric. 2020, 19, 518–527. [Google Scholar] [CrossRef]
- Yan, W.; Cao, S.; Liu, X.; Yao, G.; Yu, J.; Zhang, J.; Wu, Y. Combined Physiological and Transcriptome Analysis Revealed the Response Mechanism of Pogostemon cablin Roots to p-Hydroxybenzoic Acid. Front. Plant Sci. 2022, 13, 980745. [Google Scholar] [CrossRef] [PubMed]
- Sahrir, M.A.S.; Yusoff, N.; Azizan, K.A. Allelopathy Activity under Laboratory, Greenhouse and Field Conditions: A Review. AIMS Agric. Food 2023, 8, 78–104. [Google Scholar] [CrossRef]
- Mango, L.; Chitsika, T.; Nhete, M. Allelopathic Effects of Sorghum Species on Weed Seed Germination and Dry Matter Accumulation in Different Soil Types. Int. J. Agric. Environ. Food Sci. 2022, 6, 396–401. [Google Scholar] [CrossRef]
- Kato-Noguchi, H. Isolation and Identification of Allelochemicals and their Activities and Functions. J. Pestic. Sci. 2024, 49, 1–14. [Google Scholar] [CrossRef] [PubMed]
- Kostić, A.; Milinčić, D.; Špirović Trifunović, B.; Nedić, N.; Gašić, U.; Tešić, Ž.; Stanojević, S.; Pešić, M. Monofloral Corn Poppy Bee-Collected Pollen—A Detailed Insight into Phytochemical Composition and Antioxidant Properties. Antioxidants 2023, 12, 1424. [Google Scholar] [CrossRef] [PubMed]
- Zengin, G.; Cvetanović, A.; Gašić, U.; Dragičević, D.; Stupar, A.; Uysal, A.; Senkardes, I.; Ibrahime Sinan, K.; Picot-Allain, M.C.N.; Ak, G.; et al. UHPLC-LTQ OrbiTrap MS Analysis and Biological Properties of Origanum vulgare subsp. viridulum Obtained by Different Extraction Methods. Ind. Crops Prod. 2020, 146, 112747. [Google Scholar] [CrossRef]
- Gašić, U.; Banjanac, T.; Šiler, B.; Božunović, J.; Milutinović, M.; Aničić, N.; Dmitrović, S.; Skorić, M.; Nestorović Živković, J.; Petrović, L.; et al. Variation in the Chemical Profiles of Three Foxglove Species in the Central Balkans. Front. Plant Sci. 2023, 14, 1155297. [Google Scholar] [CrossRef] [PubMed]
- Banjanac, T.; Dragićević, M.; Šiler, B.; Gašić, U.; Bohanec, B.; Nestorović Živković, J.; Trifunović, S.; Mišić, D. Chemodiversity of Two Closely Related Tetraploid Centaurium Species and Their Hexaploid Hybrid: Metabolomic Search for High-Resolution Taxonomic Classifiers. Phytochemistry 2017, 140, 27–44. [Google Scholar] [CrossRef] [PubMed]
- Ward, J.H., Jr. Hierarchical Grouping to Optimize an Objective Function. J. Am. Stat. Assoc. 1963, 58, 236–244. [Google Scholar] [CrossRef]
- Hammer, Ø.; Harper, D.A.T.; Ryan, P.D. PAST: Paleontological Statistics Software Package for Education and Data Analysis. Paläontol. Electron. 2001, 4, 4. [Google Scholar]

| No | Compound Name | tR, min | Molecular Formula, [M–H]− | Calculated Mass, [M–H]− | Exact Mass, [M–H]− | Δ mDa | MS2 Fragments, (% Base Peak) | I | L | R | Previously Reported in Sorghum or Poaceae |
|---|---|---|---|---|---|---|---|---|---|---|---|
| Hydroxybenzoic acid derivatives | |||||||||||
| 1 | Hydroxybenzoyl hexoside 1 | 2.15 | C13H15O8− | 299.07724 | 299.07568 | 1.56 | 137.02179 *(100) | ✚ | ✚ | ✚ | [41] |
| 2 | Vanilloyl hexoside 1 | 2.96 | C14H17O9− | 329.08781 | 329.08659 | 1.22 | 108.01971(47), 121.02713(100), 123.04285(17), 152.00925(30), 167.03219(17) | ✚ | – | ✚ | [42] |
| 3 | Dihydroxybenzoyl hexoside | 3.10 | C13H15O9− | 315.07216 | 315.07099 | 1.17 | 108.01974(100), 152.00914(60) | ✚ | ✚ | ✚ | [43] |
| 4 | Dihydroxybenzoic acid 1 | 3.30 | C7H5O4− | 153.01933 | 153.01826 | 1.07 | 108.02016(100) | ✚ | ✚ | ✚ | [44] |
| 5 | Hydroxybenzoyl hexoside 2 | 3.36 | C13H15O8− | 299.07724 | 299.07578 | 1.46 | 101.02286(27), 107.04863(4), 113.02221(31), 121.02907(9), 137.02210(100), 151.03775(17), 179.03278(26) | ✚ | ✚ | ✚ | [41] |
| 6 | Syringoyl hexoside | 4.04 | C15H19O10− | 359.09837 | 359.09774 | 0.63 | 101.02225(22), 107.04837(100), 113.02147(17), 135.04300(4), 151.03719(35), 179.03365(6), 197.04271(6) | ✚ | ✚ | ✚ | [45] |
| 7 | Vanilloyl hexoside 2 | 4.25 | C14H17O9− | 329.08781 | 329.08660 | 1.20 | 108.01940(100), 123.04257(39), 152.00889(73), 167.0322(33) | ✚ | ✚ | ✚ | [42] |
| 8 | Hydroxybenzoyl hexoside 3 | 4.38 | C13H15O8− | 299.07724 | 299.07604 | 1.20 | 101.02245(34), 107.04782(5), 113.02153(35), 121.02782(10), 137.02172(100), 151.03701(18), 179.03197(46) | ✚ | ✚ | ✚ | [41] |
| 9 | Hydroxybenzoic acid | 5.66 | C7H5O3− | 137.02442 | 137.02259 | 1.83 | NA | ✚ | ✚ | ✚ | [46] |
| 10 | Hydroxybenzoyl-sucrose | 6.13 | C19H25O13− | 461.13007 | 461.13194 | −1.88 | 101.02215(4), 113.02155(7), 137.02175(100), 179.03186(3), 191.03350(4), 239.05458(5), 281.06547(15) | ✚ | ✚ | ✚ | [47] |
| 11 | Benzoyl-sucrose | 6.20 | C19H25O12− | 445.13515 | 445.13540 | −0.25 | 101.02213(100), 107.04798(100), 113.02225(77), 153.08965(20), 159.02814(15), 161.04358(52), 401.14409(5) | – | ✚ | ✚ | [47] |
| 12 | Dihydroxybenzoic acid 2 | 6.40 | C7H5O4− | 153.01933 | 153.01742 | 1.91 | 109.02747(100), 135.00666(21) | ✚ | ✚ | ✚ | [44] |
| 13 | Vanilloyl-hydroxybenzoyl-pentosyl hexoside | 6.47 | C27H31O16− | 611.16124 | 611.16848 | −7.24 | 123.04236(10), 137.02159(22), 149.02245(7), 281.06386(50), 405.11637(23), 431.09596(3), 449.10662(100) | ✚ | ✚ | ✚ | [47] |
| Hydroxycinnamic acid derivatives | |||||||||||
| 14 | 3-O-Caffeoylquinic acid 1 | 4.92 | C16H17O9− | 353.08781 | 353.08659 | 1.22 | 135.04252(91), 179.03232(39), 191.05416(100) | ✚ | – | – | [44] |
| 15 | 3-O-Caffeoylquinic acid 2 | 5.66 | C16H17O9− | 353.08781 | 353.08702 | 0.79 | 135.04364(87), 179.03342(41), 191.05464(100) | ✚ | ✚ | ✚ | [44] |
| 16 | 5-O-Caffeoylquinic acid | 6.60 | C16H17O9− | 353.08781 | 353.08714 | 0.66 | 191.05469(100) | ✚ | ✚ | ✚ | [44] |
| 17 | 3-O-Feruloylquinic acid | 6.73 | C17H19O9− | 367.10346 | 367.10263 | 0.82 | 117.03230(9), 134.03467(100), 149.05846(5), 193.04848(41) | ✚ | ✚ | ✚ | [43] |
| 18 | Methyl 5-(6″-sinapoyl-hexosyl)-O-caffeoylquinate | 6.74 | C34H39O18− | 735.21366 | 735.21953 | −5.86 | 134.03475(6), 173.04301(7), 191.05286(5), 193.04842(100), 367.10189(42) | ✚ | ✚ | ✚ | New |
| 19 | 5-(6″-Sinapoyl-hexosyl)-O-caffeoylquinic acid | 6.74 | C33H37O18− | 721.19805 | 721.20149 | −3.44 | 134.03512(6), 173.04347(31), 179.03236(18), 191.05451(17), 193.04852(100), 353.08558(27), 367.10172(46) | ✚ | ✚ | ✚ | New |
| 20 | Feruloyl hexoside | 7.00 | C16H19O9− | 355.10346 | 355.10025 | 3.21 | 134.03437(100), 150.05370(45), 160.01174(18), 175.03891(23), 178.02458(69), 191.05595(20), 193.05380(57) | ✚ | ✚ | ✚ | [48] |
| 21 | 3-O-p-Coumaroylquinic acid | 7.14 | C16H17O8− | 337.09289 | 337.09194 | 0.95 | 111.04307(9), 119.04809(25), 163.03799(20), 173.04338(5), 191.05405(100) | ✚ | ✚ | – | [49] |
| 22 | 5-O-Caffeoylshikimic acid | 7.34 | C16H15O8− | 335.07724 | 335.07999 | −2.75 | 119.04747(3), 123.00756(3), 135.04220(100), 161.02286(22), 179.03177(34) | ✚ | ✚ | – | [44] |
| 23 | 4-O-Feruloylquinic acid | 7.48 | C17H19O9− | 367.10346 | 367.10271 | 0.75 | 117.03300(5), 134.03563(44), 149.05952(3), 173.04398(39), 191.05467(100), 193.05006(22) | ✚ | ✚ | ✚ | [50] |
| 24 | 1-O-Coumaroyl-glycerol | 7.61 | C12H13O5− | 237.07685 | 237.07532 | 1.53 | 117.03245(95), 119.04838(34), 145.02727(100) | ✚ | ✚ | ✚ | [51] |
| 25 | p-Coumaric acid | 7.61 | C9H7O3− | 163.04007 | 163.03839 | 1.68 | 117.03245(7), 119.04793(100) | ✚ | ✚ | ✚ | [52] |
| 26 | 1-O-Coumaroyl-threonic acid | 8.08 | C13H13O7− | 281.06668 | 281.06817 | −1.49 | 119.04865(38), 145.02815(100), 163.03882(3) | ✚ | – | ✚ | New |
| 27 | 1,3-O-Dicaffeoylglycerol | 9.57 | C21H19O9− | 415.10346 | 415.10681 | −3.35 | 133.02686(8), 135.04281(91), 161.02224(100), 179.03278(72), 235.05948(4), 253.06927(82) | ✚ | – | – | [51] |
| 28 | 1,3-O-Coumaroyl-caffeoyl-glycerol | 10.17 | C21H19O8− | 399.10854 | 399.11036 | −1.82 | 119.04860(83), 135.04341(43), 161.02391(59), 163.03862(100), 179.03343(23), 235.05963(9), 253.07023(38) | ✚ | – | ✚ | [51] |
| 29 | 1,3-O-Feruloyl-caffeoyl-glycerol | 10.24 | C22H21O9− | 429.11911 | 429.12218 | −3.08 | 134.03469(100), 149.05746(12), 161.02354(54), 179.03264(21), 193.04838(95), 235.05871(13), 253.06913(38) | – | – | ✚ | [51] |
| 30 | Diferuloyl-sucrose tri-acetyl ester | 10.71 | C38H43O20− | 819.23480 | 819.24395 | −9.15 | 175.03719(100), 193.04834(11), 345.22234(5), 601.17274(5), 643.18493(5), 759.20662(9), 777.22535(13) | – | – | ✚ | [47] |
| 31 | 1,3-O-Dicoumaroyl-glycerol | 10.78 | C21H19O7− | 383.11363 | 383.11644 | −2.81 | 117.03274(8), 119.04859(100), 145.02787(63), 163.03835(96)), 219.06400(5), 237.07500(4) | ✚ | ✚ | ✚ | [51] |
| 32 | 1,3-O-Coumaroyl-feruloyl-glycerol | 10.85 | C22H21O8− | 413.12419 | 413.12638 | −2.19 | 119.04865(67), 134.03559(100), 145.02800(43), 160.01616(15), 163.03853(65), 175.03858(23), 193.04918(59) | ✚ | ✚ | ✚ | [51] |
| 33 | 1,3-O-Diferuloyl-glycerol | 10.98 | C23H23O9− | 443.13476 | 443.13512 | −0.37 | 134.03582(99), 135.04012(12), 149.05882(20), 160.01751(16), 175.03815(35), 193.04941(100) | ✚ | ✚ | ✚ | [51] |
| 34 | Diferuloyl-sucrose tetra-acetyl ester | 11.66 | C40H45O21− | 861.24588 | 861.24459 | 1.29 | 175.03794(100), 193.04839(9), 625.17540(4), 643.18719(5), 685.19914(4), 801.22476(15), 819.2327(14) | ✚ | ✚ | ✚ | [47] |
| Flavonoid glycosides | |||||||||||
| 35 | Quercetin 3,4′-di-O-hexoside | 6.80 | C27H29O17− | 625.14051 | 625.14821 | −7.71 | 166.04827(28), 191.05588(9), 210.04103(14), 211.02269(68), 300.02160(16), 301.03319(54), 463.08475(100) | ✚ | – | – | [51] |
| 36 | Luteolin 7-O-(2″-pentosyl)-hexoside | 7.27 | C26H27O15− | 579.13502 | 579.13964 | −4.63 | 369.05905(85), 399.0697(95), 429.08014(30), 441.08052(23), 459.09156(100), 471.09038(8), 489.10134(43) | ✚ | ✚ | – | [53] |
| 37 | Apigenin 6-C-hexoside−8-C-pentoside | 7.54 | C26H27O14− | 563.14010 | 563.14763 | −7.52 | 149.04288(22), 353.06485(100), 383.07530(77), 425.08417(19), 443.09686(46), 473.10771(49), 503.11826(27) | ✚ | ✚ | ✚ | [43] |
| 38 | Luteolin 3′,7-di-O-hexoside | 7.69 | C27H29O16− | 609.14569 | 609.15500 | −9.31 | 147.02457(7), 175.09716(12), 191.05255(84), 284.03316(18), 285.03694(100), 286.04299(22), 447.09260(68) | – | ✚ | – | [54] |
| 39 | Eriodictyol 7-O-hexoside | 8.08 | C21H21O11− | 449.10894 | 449.10916 | −0.22 | 135.04244(16), 151.00178(46), 152.00506(6), 217.10833(11), 286.03948(81), 287.04418(100) | ✚ | – | – | [51] |
| 40 | Quercetin 3-O-hexoside | 8.08 | C21H19O12− | 463.08778 | 463.09585 | −8.07 | 151.00124(4), 161.02153(3), 178.99940(3), 255.02771(6), 271.02293(12), 300.02573(100), 301.03248(49) | ✚ | – | – | [55] |
| 41 | Luteolin 7-O-hexoside | 8.12 | C21H19O11− | 447.09329 | 447.09491 | −1.63 | 284.03043(39), 285.03801(100), 286.04177(19) | ✚ | ✚ | – | [51] |
| 42 | Chrysoerol 6-C-hexoside | 8.15 | C22H21O11− | 461.10842 | 461.11514 | −6.72 | 109.02603(29), 131.03546(27), 151.03529(26), 298.04661(73), 299.05206(18), 313.06695(26), 341.06476(100) | ✚ | ✚ | ✚ | [56] |
| 43 | Chrysoerol 7-O-(6″-rhamnosyl)-hexoside | 8.62 | C28H31O15− | 607.16633 | 607.17486 | −8.53 | 284.03045(15), 299.05329(100) | ✚ | – | – | New |
| 44 | Luteolin 7-O-(6″-caffeoyl)-hexoside | 9.10 | C30H25O14− | 609.12445 | 609.12966 | −5.20 | 161.02202(7), 179.03113(4), 285.03821(100), 323.07656(8), 447.08988(5) | – | ✚ | – | New |
| 45 | Tricin 4′-O-(erythro-guaiacylglyceryl) ether | 10.65 | C27H25O11− | 525.14024 | 525.14179 | −1.55 | 165.05354(100), 195.06397(20), 299.01771(31), 313.03283(11), 314.04096(87), 329.06420(94) | ✚ | ✚ | – | [57] |
| Flavonoid aglycones | |||||||||||
| 46 | Luteolin | 9.77 | C15H9O6− | 285.04046 | 285.04093 | −0.47 | 107.01180(15), 133.02738(100), 149.02202(12), 151.00143(30), 175.03779(14), 199.03763(11), 217.04828(7) | ✚ | ✚ | ✚ | [51] |
| 47 | Quercetin | 9.84 | C15H9O7− | 301.03483 | 301.04473 | −9.90 | 107.01242(38), 121.02829(41), 151.00186(100), 178.99758(13), 215.03478(15), 243.02878(25), 257.04214(15) | ✚ | – | ✚ | [44] |
| 48 | Apigenin | 10.45 | C15H9O5− | 269.04555 | 269.04626 | −0.72 | 107.01209(38), 117.03234(100), 121.02679(8), 149.02139(25), 151.00092(55), 227.03471(5) | – | ✚ | ✚ | [44] |
| 49 | Tricin | 10.58 | C17H13O7− | 329.06668 | 329.06783 | −1.15 | 161.02155(11), 227.03264(18), 243.02701(5), 271.02265(44), 299.01787(100), 314.04066(14) | ✚ | ✚ | ✚ | [44] |
| 50 | Chrysoerol | 10.65 | C16H11O6− | 299.05611 | 299.05692 | −0.81 | 107.01199(4), 151.00100(5), 227.03333(5), 256.03499(67), 284.02993(100) | – | ✚ | ✚ | [51] |
| Fatty acids | |||||||||||
| 51 | Trihydroxyoctadecadienoic acid 1 | 10.38 | C18H31O5− | 327.21770 | 327.21612 | 1.58 | 127.11013(11), 137.09409(17), 171.10022(100), 183.13578(27), 193.11929(8), 211.13147(96), 229.14154(28) | ✚ | ✚ | ✚ | [44] |
| 52 | Trihydroxyoctadecenoic acid 1 | 10.78 | C18H33O5− | 329.23335 | 329.23111 | 2.24 | 127.11068(20), 139.11053(55), 171.10041(100), 183.13661(15), 193.12133(5), 211.13164(70), 229.1424(22) | ✚ | ✚ | ✚ | [51] |
| 53 | Trihydroxyoctadecadienoic acid 2 | 11.45 | C18H31O5− | 327.21770 | 327.21646 | 1.24 | 127.11043(27), 137.09476(29), 155.10512(28), 171.09991(100), 199.13045(17), 201.11053(45), 209.1163(10) | ✚ | – | ✚ | [44] |
| 54 | Trihydroxyoctadecenoic acid 2 | 11.59 | C18H33O5− | 329.23335 | 329.23176 | 1.58 | 127.11083(36), 139.11058(20), 155.10565(13), 171.10051(100), 199.12978(17), 201.11123(89), 293.2088(8) | ✚ | ✚ | ✚ | [51] |
| 55 | Dihydroxyoctadecenoic acid 1 | 13.07 | C18H33O4− | 313.23843 | 313.23540 | 3.03 | 127.11086(45), 129.08937(59), 171.10008(33), 183.13717(100), 251.19894(26), 277.21524(32), 295.22696(58) | ✚ | – | ✚ | [51] |
| 56 | Dihydroxyoctadecenoic acid 2 | 13.34 | C18H33O4− | 313.23843 | 313.23702 | 1.42 | 127.07463(11), 129.09035(48), 183.13746(100), 195.13807(7) | ✚ | ✚ | ✚ | [51] |
| 57 | Dihydroxyoctadecenoic acid 3 | 13.48 | C18H33O4− | 313.23843 | 313.23616 | 2.27 | 127.11053(30), 139.11077(4), 171.10026(22), 199.09509(9), 201.11113(100), 277.21547(9) | ✚ | ✚ | ✚ | [51] |
| 58 | Dihydroxyoctadecadienoic acid | 13.75 | C18H31O4− | 311.22278 | 311.22116 | 1.63 | 127.11004(19), 139.10962(27), 171.10031(100), 185.11572(10), 197.11536(12), 201.11167(14), 211.12991(14) | ✚ | ✚ | ✚ | [51] |
| Lignans | |||||||||||
| 59 | Oryzativol A | 11.39 | C40H39O13− | 727.23962 | 727.24698 | −7.36 | 119.04759(26), 145.02738(21), 163.03750(100), 515.16625(8), 545.18149(61), 709.23082(4) | – | – | ✚ | [58] |
| 60 | Oryzativol B | 13.07 | C40H39O13− | 727.23962 | 727.24193 | −2.31 | 119.04820(24), 145.02674(30), 163.03781(100), 581.20291(4) | – | – | ✚ | [58] |
Disclaimer/Publisher’s Note: The statements, opinions and data contained in all publications are solely those of the individual author(s) and contributor(s) and not of MDPI and/or the editor(s). MDPI and/or the editor(s) disclaim responsibility for any injury to people or property resulting from any ideas, methods, instructions or products referred to in the content. |
© 2025 by the authors. Licensee MDPI, Basel, Switzerland. This article is an open access article distributed under the terms and conditions of the Creative Commons Attribution (CC BY) license (https://creativecommons.org/licenses/by/4.0/).
Share and Cite
Nestorović Živković, J.; Simonović, M.; Mišić, D.; Nešić, M.; Jovanović, V.; Gašić, U.; Bjedov, I.; Dmitrović, S. Bioherbicidal Evaluation of Methanol Extract of Sorghum halepense L. Rhizome and Its Bioactive Components Against Selected Weed Species. Molecules 2025, 30, 3060. https://doi.org/10.3390/molecules30153060
Nestorović Živković J, Simonović M, Mišić D, Nešić M, Jovanović V, Gašić U, Bjedov I, Dmitrović S. Bioherbicidal Evaluation of Methanol Extract of Sorghum halepense L. Rhizome and Its Bioactive Components Against Selected Weed Species. Molecules. 2025; 30(15):3060. https://doi.org/10.3390/molecules30153060
Chicago/Turabian StyleNestorović Živković, Jasmina, Milica Simonović, Danijela Mišić, Marija Nešić, Vladan Jovanović, Uroš Gašić, Ivana Bjedov, and Slavica Dmitrović. 2025. "Bioherbicidal Evaluation of Methanol Extract of Sorghum halepense L. Rhizome and Its Bioactive Components Against Selected Weed Species" Molecules 30, no. 15: 3060. https://doi.org/10.3390/molecules30153060
APA StyleNestorović Živković, J., Simonović, M., Mišić, D., Nešić, M., Jovanović, V., Gašić, U., Bjedov, I., & Dmitrović, S. (2025). Bioherbicidal Evaluation of Methanol Extract of Sorghum halepense L. Rhizome and Its Bioactive Components Against Selected Weed Species. Molecules, 30(15), 3060. https://doi.org/10.3390/molecules30153060

